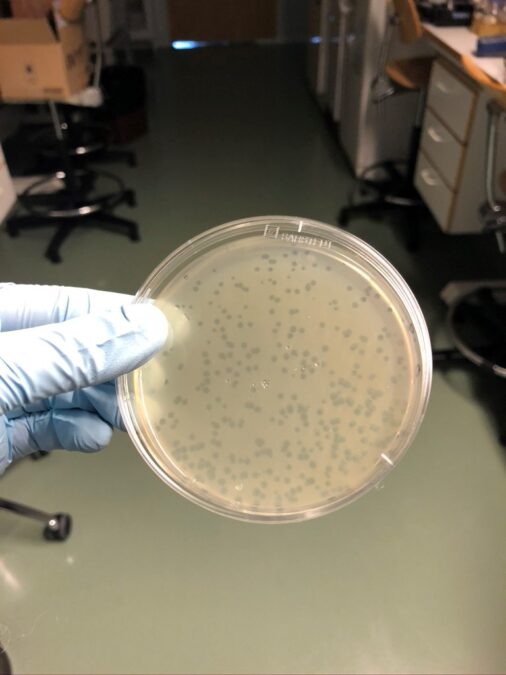

Faagit taltuttavat viljelykalojen bakteeritaudin
Jyväskylän yliopiston apulaisprofessori Lotta-Riina Sundberg kehittää tutkimusryhmänsä kanssa hoitokeinoa tuotantotappioita aiheuttavaan kalatautiin. Ryhmä tutkii, miten faageja voidaan hyödyntää viljelykalojen kivuliaita iho- ja kidustulehduksia aiheuttavan flavobakteeri torjunnassa.
Lupaavia tuloksia on saatu kyllästämällä kaloja faageilla ennen bakteeritaudin puhkeamista. Faagit tarttuvat kalan pintalimaan.
− Faagit eli bakteriofagit ovat bakteereita infektoivia viruksia. Ne lisääntyvät vain tietyssä isäntäbakteerissa, eivätkä kykene infektoimaan ihmisiä, eläimiä tai kasveja. Koska faagit ovat spesifejä, niiden avulla voidaan poistaa vain haluttuja bakteereita, kuten taudinaiheuttajia. Antibiootteihin verrattuna haitat muulle mikrobistolle ovat olemattomia; antibioottien käyttö tuhoaa myös hyviä tai tarpeellisia bakteereita, Sundberg tarkentaa.
Hänen ryhmänsä tutkii faagien käyttöä flavobakteeri-infektioiden torjuntaan ja hoitoon. Menetelmää on testattu kirjolohilla läpivirtausakvaarioissa laboratoriossa.
− Faagin lisääminen akvaarioveteen on hyvin tehokas keino torjua tautia. Faageja voidaan myös ”istuttaa” kalan iholimaan kylvetyksellä. Ne antavat ennaltaehkäisevän suojan bakteeri-infektiota vastaan useamman päivän ajaksi. Faagihoito tehoaa myös, jos se annetaan jo puhjenneen taudin aikana, Sundberg kertoo.
Faageja voidaan antaa kaloille myös rehussa, tai kiinnittää niitä kalanviljelyaltaan pintoihin.
EU-lainsäädäntö hidastaa käyttöönottoa
Sundbergin työryhmä on tehnyt yhteistyötä Luonnonvarakeskuksen tutkijoiden kanssa ja testannut, miten hyvin faagi selviytyy kiertovesiviljelyolosuhteissa. Näissä kokeissa ei ollut bakteeria mukana, mutta altaisiin lisättyä faagia löytyi suodatinmateriaaleista jopa kolme viikkoa lisäyksen jälkeen.
− Kiertovesikasvatukseen faagi varmasti sopisi hyvin, koska se ei häiritse filttereiden mikrobistoa. Tällä hetkellä EU-lainsäädäntö näkee faagit kuitenkin lääkeaineena, Sundberg sanoo.
Edessä voi olla vielä pitkä tie, ennen kuin faageja päästään käyttämään kalanviljelylaitoksilla.
− Se on varmasti useamman vuoden prosessi kliinisine kokeineen ja tuotantomenetelmien standardointeineen, Sundberg arvioi.
Toisaalta EU on hiljattain sallinut faagien käytön valmisruokapakkauksissa, joissa niillä torjutaan kontaminaatiota, esimerkiksi Listeriaa.
− Micreoksen tuotteet ovat käytössä jo USA:ssa valmiiksi pakatuissa ruuista, joissa niillä on Yhdysvaltojen elintarvike- ja lääkeviraston, FDA:n, hyväksyntä ja joissa ne on todettu turvalliseksi. Euroopan unionin tuomioistuin, European court of Justice, on päättänyt, että Listex-tuotetta voi käyttää Listerian kasvun ehkäisyyn, Sundberg täsmentää.
Hän toivoo, että hyvät kokemukset faageista tuovat lainsäädäntöön toisenlaista linjaa.
− Faageja saa antaa ihmisille, jos mitään muuta tehokasta hoitoa ei ole enää jäljellä, mutta kala selkärankaisena eläimenä jää näiden näkemysten väliin. Olen kuitenkin odottavalla mielellä. Jos faagien käyttö vapautuu, meillä on jo tutkittu menetelmä valmiina, Sundberg kertoo.
Hänen mukaansa faageista voi olla apua myös koronavirustaudin hoidossa.
− Koronaviruksen seurauksena voi tulla bakteeriperäisiä tulehduksia, joihin antibiootit eivät välttämättä pure. Jos lääkkeet eivät auta, voidaan faageja antaa potilaille.
Faageista lääkkeitä antibioottien tilalle
Bakteereja tuhoavat virukset eli faagit löydettiin jo sata vuotta sitten. Luonnossa bakteerit ja faagit käyvät jatkuvaa keskinäistä taistelua. Jokaisella bakteerilla on oma faaginsa, joka pystyy tuhoamaan sen. Bakteerit torjuvat niiden sisälle pyrkiviä faageja esimerkiksi tuottamalla viruksia pilkkovia proteiineja. Faagit taas yrittävät harhauttaa bakteereja päästäkseen lisääntymään isäntäbakteerissa.
Taistelusta jää jälki bakteerin perimään, genomiin. Viruksen perimästä siirtyy DNA-jaksoja niin kutsuttuun CRISPR-systeemiin (Clustered Regularly Interspaced Short Palindromic Repeats). Näiden jaksojen avulla voi löytyä juuri oikeanlainen faagi, joka taltuttaa tautia aiheuttavia bakteereita.
CRISPR tarjoaa myös geenimuuntelutekniikoita, ”geenisaksia”, joilla genomia voidaan muokata. Sundbergin tutkimusryhmä ei käytä geenisaksia, vaan selvittää, miten CRISPR toimii luontaisesti bakteereissa.
Solu- ja molekyylibiologia imaisi kalabiologin
Lotta-Riina Sundbergin tutkijan ura alkoi akvaattisten tieteiden opiskelulla Jyväskylän yliopiston bio- ja ympäristötieteiden laitoksella vuonna 1997, mutta solu- ja molekyylibiologia imaisi kalabiologin mukaansa. Sundberg väitteli vuonna 2005 filosofian tohtoriksi flavobakteerista. Nyt hän vetää Jyväskylän yliopistossa aiheeseen pureutuvaa tutkimusryhmää.
Sundberg eristi ensimmäisen flavobakteeria infektoivan faagin Jyväskylän yliopiston Nanotiedekeskuksen laboratoriossa vuonna 2007. Siitä lähtien tutkimusryhmä on kerännyt näytteitä bakteerin ja faagin kamppailusta suomalaisilta kalanviljelylaitoksilta.
Sundberg sai tutkimuksiinsa nelivuotisen rahoituksen Suomen Akatemialta vuonna 2018. Tutkimusta rahoittavat myös Jane ja Aatos Erkon säätiö, Itämeren tutkimus- ja kehitysohjelma (BONUS) ja Euroopan meri- ja kalatalousrahasto (EMKR). Faagin tuotantomenetelmistä on tehty kansainvälinen patenttihakemus.
Suosittelemme artikkelia
